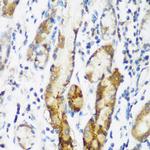
NAT15 Antibody in Immunohistochemistry (Paraffin) (IHC (P))

Search
Invitrogen
NAT15 Polyclonal Antibody
{{$productOrderCtrl.translations['antibody.pdp.commerceCard.promotion.promotions']}}
{{$productOrderCtrl.translations['antibody.pdp.commerceCard.promotion.viewpromo']}}
{{$productOrderCtrl.translations['antibody.pdp.commerceCard.promotion.promocode']}}: {{promo.promoCode}} {{promo.promoTitle}} {{promo.promoDescription}}. {{$productOrderCtrl.translations['antibody.pdp.commerceCard.promotion.learnmore']}}
图: 1 / 4
NAT15 Antibody (PA5-96660) in IHC (P)

Please note: We are reviewing Western blot images included in the antibody testing data in our catalog, including those provided by third parties. Unless expressly labeled or annotated as “raw-unedited”, Western blot images included in the antibody testing data in our catalog may have been edited, optimized or otherwise adjusted for presentation.
产品信息
PA5-96660
种属反应
宿主/亚型
分类
类型
抗原
偶联物
形式
浓度
规格
纯化类型
保存液
内含物
保存条件
运输条件
RRID
产品详细信息
Positive Samples: Mouse brain, Rat brain; Cellular Location: Golgi apparatus membrane
Immunogen sequence: MTEVVPSSAL SEVSLRLLCH DDIDTVKHLC GDWFPIEYPD SWYRDITSNK KFFSLAATYR GAIVGMIVAE IKNRTKIHKE DGDILASNFS VDTQVAYILS LGVVKEFRKH GIGSLLLESL KDHISTTAQD HCKAIYLHVL TTNNTAINFY ENRDFKQHHY LPYYYSIRGV LKDGFTYVLY INGG
靶标信息
Histone acetyltransferase localized in the Golgi apparatus that mediates acetylation of free histone H4, thereby facilitating nucleosome assembly. Has a preference for free histone H4 'Lys-20'(H4K20ac), 'Lys-79'(H4K79ac) and 'Lys-91' (H4K91ac). Also displays alpha (N-terminal) acetyltransferase activity towards a range of N-terminal sequences including those starting with Met-Lys, Met-Val, Met-Ala and Met-Met. Required for normal chromosomal segregation during anaphase.
仅用于科研。不用于诊断过程。未经明确授权不得转售。
篇参考文献 (0)
生物信息学
蛋白别名: GNAT acetyltransferase; GNAT acetytransferase; HAT4; Histone acetyltransferase type B protein 4; N-acetyltransferase 15; N-acetyltransferase 15 (GCN5-related, putative); N-alpha-acetyltransferase 60; N-alpha-acetyltransferase F; NatF; natF catalytic subunit
基因别名: 1200013P24Rik; AI315146; Naa60; Nat15; RGD1308915
UniProt ID: (Mouse) Q9DBU2, (Rat) Q3MHC1
Entrez Gene ID: (Mouse) 74763, (Rat) 363545




